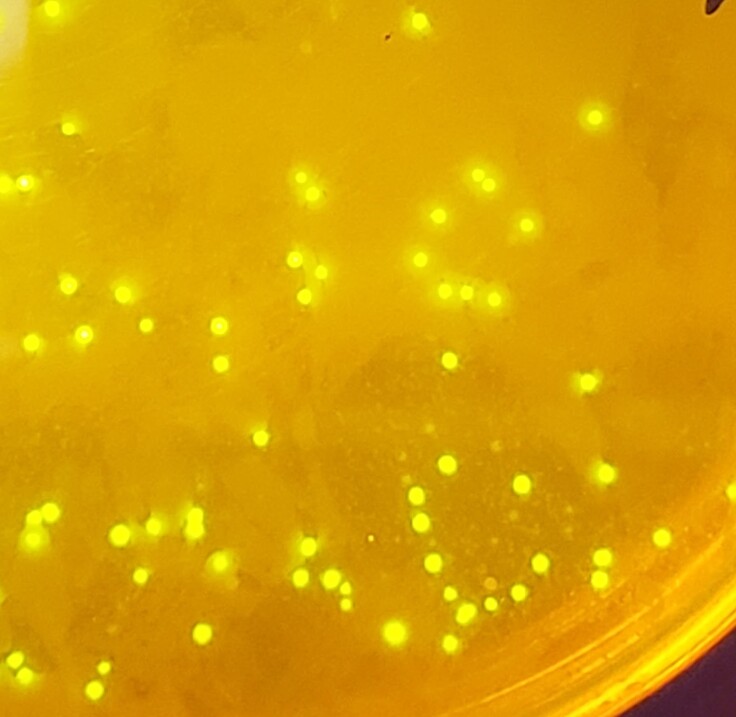

寄付総額
目標金額 1,920,000円
- 寄付者
- 169人
- 募集終了日
- 2023年9月30日
メンバー紹介:長谷彩沙
初めまして、九州大学工学府修士2年の長谷彩沙(ながたに あやさ)です。
私の研究は、人工タンパク質で環境にやさしい材料をつくることです。タンパク質と光って関係するのか?と思う人もいると思います。でも、光るタンパク質もあって、私はそれを使って実験をしています。(写真は大腸菌のかたまりなのですが、大腸菌内で蛍光タンパク質が作られているので光ってます!)
ここからは私がなぜ化学を専攻しているのかについて話したいと思います。私は、学部の頃から九州大学というわけではなく、高校と大学の学部時代を高専で過ごしました。なので、高校生活も送っていません(笑)

高専というのは、5年制の学校で、高校一年生の頃から専攻する学科の専門的な授業があるような少し特殊な学校です。なので、私は中学生の時に化学を専攻すると決めていたことになります。
なぜ、中学生の私が化学を専攻しようとしたのか?ですが、正直中学生の頃の自分を覚えていません。ただ、高専を選んだのはどうせ大学で何かの学問を選択するなら早めに選んでいてもいいのではないか、とかそんな感じだと思います。そして、学科が様々ある中で化学をえらんだとのは、、正直なんとなくです。将来のことをなんとなくで決めるのはよくないのかもしれません(笑)。でも、化学を選択したことを後悔したことは一回もないです。そして、このなんとなくの選択肢って実は大事なんじゃないかと最近感じます。何択か選択肢があったとき、絶対これ!って思うことの方が少ないと思います。そんな時は、なんとなくこれかなと思い決めることもあると思います。私がなんとなくで化学を選んだのも、実家と科学館が近く、遊びに行っていたのもあるのかなとか、あといろんな種類の図鑑も家にたくさんあったり、、。割と幼少期の環境って将来の選択に影響を及ぼしていると今更ながら感じます。
色々話しましたが、結局何が言いたいかというと、小・中・高校生の将来のなんとなくの選択に影響及ぼす時期に、化学を知ってもらうのがこの活動だと思います。そして、だれかのなんとなく化学!を選択するきっかけになるようメンバーの一員として頑張りたいと思います!!
ギフト
3,000円+システム利用料

応援コースA
●寄付金領収書
●感謝のメール
●報告書のメール送付
●ホームページにお名前を掲載(希望する方のみ)
- 申込数
- 47
- 在庫数
- 制限なし
- 発送完了予定月
- 2025年3月
10,000円+システム利用料

応援コースB
●寄付金領収書
●感謝のメール
●報告書のメール送付
●ホームページにお名前を掲載(希望する方のみ)
- 申込数
- 99
- 在庫数
- 制限なし
- 発送完了予定月
- 2025年3月
3,000円+システム利用料

応援コースA
●寄付金領収書
●感謝のメール
●報告書のメール送付
●ホームページにお名前を掲載(希望する方のみ)
- 申込数
- 47
- 在庫数
- 制限なし
- 発送完了予定月
- 2025年3月
10,000円+システム利用料

応援コースB
●寄付金領収書
●感謝のメール
●報告書のメール送付
●ホームページにお名前を掲載(希望する方のみ)
- 申込数
- 99
- 在庫数
- 制限なし
- 発送完了予定月
- 2025年3月

通常医療が提供困難な状況で、1人でも多くの命を救うプロジェクト
- 総計
- 11人

「科学の芽」賞と子どもたちの「好き」を一緒に応援しませんか?
- 現在
- 1,900,000円
- 寄付者
- 95人
- 残り
- 10日

子どもの心と学び支援を展開したい!AISES子ども支援サポーター
- 総計
- 1人

【毎日営業の第三の居場所】地球の子供食堂と宿題Cafeひがしく店
- 総計
- 62人

「人間とは何か?」を学際的に問い直すーCHAIN異分野融合教育支援
- 現在
- 934,000円
- 寄付者
- 66人
- 残り
- 23日

医療の未来を守り、育てる。膵がん治療の開発・力ある若手外科医の育成
- 現在
- 17,613,000円
- 寄付者
- 350人
- 残り
- 15日

生まれつきの心臓の病気「先天性心疾患」 遺伝子解析から未来の医療へ
- 現在
- 8,403,000円
- 寄付者
- 242人
- 残り
- 29日













